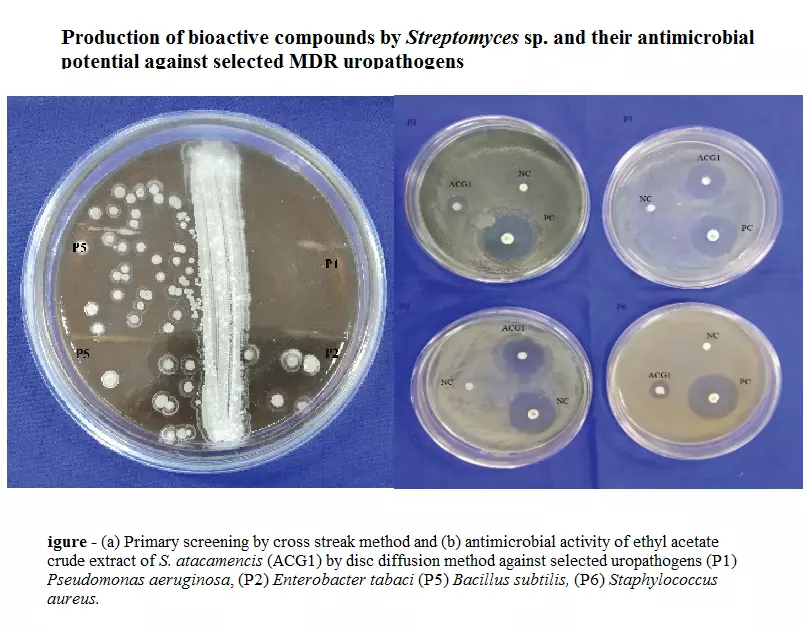
Graphical Abstract

Bioactivity assessment of endophytic fungi associated with Centella asiatica and Murraya koengii
Archana Nath, Jyoti Pathak and SR Joshi
DOI: 10.7324/JABB.2014.2502Pages: 006-011

Medicinal and Functional Values of Thyme (Thymus vulgaris L.) Herb
Eqbal M. A. Dauqan, Aminah Abdullah
DOI: 10.7324/JABB.2017.50203Pages: 017-022

Chemical composition, antioxidant and antimicrobial activities of the essential oil of Vetiveria nigritana (Benth.) Stapf roots from Burkina Faso
Zenabou Semde, Jean Koudou, Cheikna Zongo, Gilles Figueredo, Marius K. Somda, Leguet Ganou, Alfred S. Traore
DOI: 10.7324/JABB.2017.50405Pages: 029-036

Antimicrobial applications of sophorolipid from Candida bombicola: A promising alternative to conventional drugs
Victoria Akemi Itakura Silveira, Christiane Aparecida Urzedo Queiroz Freitas, Maria Antonia Pedrine Colabone Celligoi
DOI: 10.7324/JABB.2018.60614Pages: 87-90

Antibacterial potential of Caesalpinia bonducella extracts and their isolated phytoconstituents: in vitro and in silico analysis
S R Santosh Kumar, Sudhesh L Shastri, Venkatesh R, K Pradeepa, V Krishna
DOI: 10.7324/JABB.2019.70308Pages: 41-46

Phytochemical analysis, antimicrobial and antioxidant activities of Aidia borneensis leaf extracts
Zulhamizan Awang-Jamil, Aida Maryam Basri, Norhayati Ahmad, Hussein Taha
DOI: 10.7324/JABB.2019.70515Pages: 92-97

Partial purification and characterization of antimicrobial peptide from the hemolymph of cockroach Periplaneta americana
Reymend Encily Martin, Yogita Raosaheb Channe
DOI: 10.7324/JABB.2020.80202Pages: 6-11

Enhanced production of a bioactive molecule from a symbiotic marine bacterium, Paenibacillus macerans SAM 9 isolated from the sea anemone, Heteractis aurora
Thayanithi Bharathi, Kathirvelu Sambandan, Kandasamy Sivasubramani
DOI: 10.7324/JABB.2021.9103Pages: 17-24

Antimicrobial, anti-inflammatory, and anticancer activities of leaves extracts of Filicium decipiens
Atiyaparveen I Basarikatti, Sanjay Mishra, Vijaykumar Uppar, Basavaraj Padmashali
DOI: 10.7324/JABB.2021.9111Pages: 83-87

The comparative antimicrobial and anticancer of chemical extract from in vitro and in vivo Peperomia pellucida plantlet
Lydia Teoh, Nareshwaran Gnanasegaran, Ahmad Faris Mohd Adnan, Rosna Mat Taha
DOI: 10.7324/JABB.2021.9210Pages: 115-123

Screening of synergistic and antimicrobial effect of Cr (VI) and Ni (II) tolerant bacteria Bacillus cereus
Subhayan Dutta, Khaleda Firdous, Swati Chakraborty
DOI: 10.7324/JABB.2021.9409Pages: 69-77

Production of bioactive compounds by Streptomyces sp. and their antimicrobial potential against selected MDR uropathogens
Archana Singh, Padma Singh
DOI: 10.7324/JABB.2021.9609Pages: 71–79
Diversity and antimicrobial potential of endophytic fungi from aromatic plants of Bhadra Wildlife Sanctuary, Western Ghats, Karnataka
Rajeshwari Jagadish, Srinivas Chowdappa
DOI: 10.7324/JABB.2021.9501Pages: 1-12

A review on fish peptides isolated from fish waste with their potent bioactivities
Ayusman Behera, Rajashree Das, Pranati Patnaik, Jyotirmaya Mohanty, Gargee Mohanty
DOI: 10.7324/JABB.2022.100323Pages: 195-209

Leveraging monoclonal antibodies as therapeutics to address antimicrobial resistance in bacteria
Vaishali Verma
DOI: 10.7324/JABB.2023.90087Pages: 53-60

Antimicrobial potential of Indian cooperative spider, Stegodyphus sarasinorum, and Golden orb spider, Nephila pilipes hemolymph against pathogenic bacteria
Dhanapal Sangavi, Padur Sankaranarayanan Anisha, Douglas J. H. Shyu, Parthasarathy Thiruchenthil Nathan
DOI: 10.7324/JABB.2023.132509Pages: 159-163

A novel trypsin inhibitor peptide MoCh I with antimicrobial activity derived from Momordica charantia
Samriti Dogra, Rajesh Biswas, Rupinderjeet Kaur, Sangeeta Sharma, Kakoli Biswas
DOI: 10.7324/JABB.2023.135088Pages: 213-220

Isolation of yeast endophytes from healthy seeds of Capsicum annuum L. and assessment of their antimicrobial activity
Barbi Bhuyan, Purthimi Kungri Hansepi, Suraiya Akhtar, Raja Ahmed, Rafiul Amin Laskar, Kumanand Tayung
DOI: 10.7324/JABB.2023.107607Pages: 111-116

Metabolic profile, bioactivities, and variations in chemical constituents of essential oils of twenty mango ginger (Curcuma amada) accessions
Jyotirmayee Lenka, Snehalata Khuntia, Basudeba Kar, Suprava Sahoo
DOI: 10.7324/JABB.2023.129372Pages: 147-157

Investigating plasmid-mediated antimicrobial resistance in gut microbes: A focus on Prevotella and Bifidobacterium
Jayavigneshwar Natarajan, Sorna Lakshmi S, Ishaan Ramachandran, Devika Sharma, Bhuvaneshwaran Rajaguru, Priya Swaminathan
DOI: 10.7324/JABB.2024.147983Pages: 150-158

Solid-state fermentation of pigment producing endophytic fungus Fusarium solani from Madiwala lake and its toxicity studies
Bhoomika Prakash Poornamath, Suma Sarojini, Saranya Jayaram, Soma Biswas, Anand Kaloor, Mridul Umesh
DOI: 10.7324/JABB.2024.143030Pages: 264-272

Exploring Bougainvillea glabra flowers: a promising source of natural antimicrobial and anticancer agents
Wanchat Sirisarn, Auemphon Mordmuang, Kankamol Kerdkumthong, Sompop Saeheng
DOI: 10.7324/JABB.2024.195322Pages: 174-184

Production of recombinant OXA-23 carbapenemase: a target for developing antibody-based diagnostics against carbapenem-resistant Acinetobacter baumannii
Abhishek Kasana, Brinda Bhardwaj, Vaishali Verma
DOI: 10.7324/JABB.2024.187605Pages: 291-298

Characterization of the bioactive components of Chloris virgata Sw. and assessment of its antimicrobial and anti-arthritic potential
Dolly Kumari, Priya Chaudhary, Priya Yadav, Pracheta Janmeda
DOI: 10.7324/JABB.2024.195146Pages: 135-142

Antimicrobial peptides as new antibiotics: A comprehensive review
Amanpreet Thakur, Puja Gupta
DOI: 10.7324/JABB.2025.210174Pages: 22-33

Identification, antimicrobial activity, and mycochemicals of Lentinus spp. cultivated in papaya peel medium
Alivia Nur Maysaroh, Lucia Dhiantika Witasari, Sari Darmasiwi
DOI: 10.7324/JABB.2025.213846Pages: 104-112

Purification and characterization of bioactive compound from Euphorbia heyneana Spreng extracts
Amit Lath, Sanjit Boora, Jitendra Kumar Sharma, Ankita Grover, Khemchand Yadav, Anita Rani Santal, Nater Pal Singh
DOI: 10.7324/JABB.2025.238191Pages: 110-117

Green synthesis of silver nanoparticles using soil bacteria and its antibacterial potential
Charu Gupta, Mahendra K. Gupta, Shivani Tripathi
DOI: 10.7324/JABB.2025.v13.i6.21Pages: 179-186

Isolation and functional evaluation of probiotic bacteria from goat milk: A small ruminant-derived resource for animal and human health applications
Kusuma Kandati, Deva Prasad Raju Borelli, Viswanath Buddolla, John Sushma Nannepaga
DOI: 10.7324/JABB.2026.264555Pages: 185-194

Purification and characterization of plantaricin K-2 from Lactiplantibacillus plantarum K-2 isolated from locally fermented cabbage
Khonsuluv A. Sohibnazarova, Muzaffar Muminov, Iskandar Yakubov, Azimjon Abdunabiev, Shakhnoza Umarova, Jakhongirbek Gulomov, Yulduz Abduvokhidova, Urmonalieva Shakhlo, Ibragimova Shakhnoza, Akmal M. Asrorov, Fazliddin Kobilov, Bozorov Soyibjon, Dilbar Dalimova, Shakhlo Miralimova
DOI: 10.7324/JABB.2026.269482Pages: 166-174

Design, in silico modeling, and in vitro evaluation of a novel antimicrobial peptide (QLSNGLFVDYLWW)
Sergey Tikhonov, Olga Babich, Natalya Tikhonova, Irina Chernukha, Mukesh Kumar Awasthi, Stanislav Sukhikh
DOI: 10.7324/JABB.2026.264169Pages: 86-91
